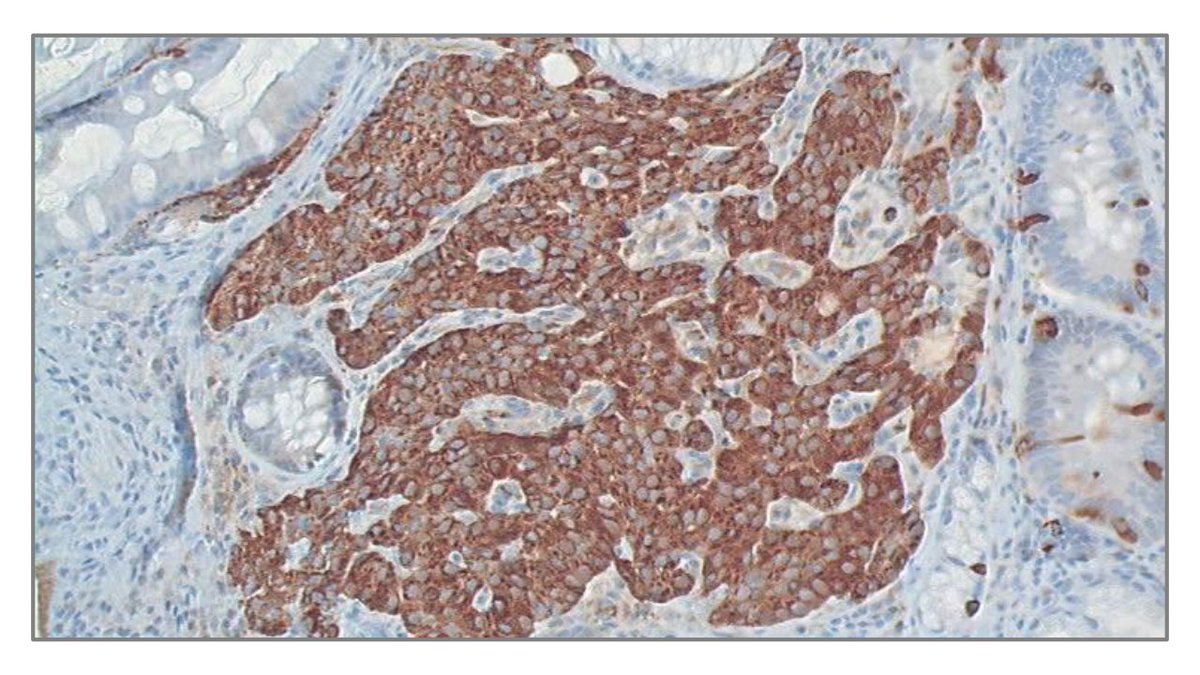
🎓 Il reste des places pour vous inscrire au DIU Tumeurs endocrines de <a href="/GustaveRoussy/">Gustave Roussy</a>, <a href="/UnivParisSaclay/">Université Paris-Saclay</a> et <a href="/univ_paris_cite/">Université Paris Cité</a>

Formez-vous dans ce domaine faisant appel à des compétences en biologie, imagerie, génétique, chirurgie...

Inscription : tinyurl.com/2zb5jbjd

#Cancer

Matthieu FARON
@statsurgeon
MD, PhD, Surgical Oncologist and Biostatistician at Gustave Roussy Cancer Campus and INSERM 1018 ONCOSTAT.
Special interest in NETs, Adrenal glands and Sarcoma
ID: 765616271002066944
16-08-2016 18:28:38
447 Tweet
193 Takipçi
172 Takip Edilen



📅 La 32ème journée de #cancérologie endocrinienne et de médecine nucléaire organisée par Gustave Roussy et l' Université Paris-Saclay aura lieu le 29 mars. Cette journée sera l'occasion de discuter autour des progrès récents en médecine nucléaire. Inscription : tinyurl.com/y3zp782f


.Gustave Roussy is recruiting a Clinical Investigator / Physician Scientist in Immuno-Oncology, Early Drug Development Center (DITEP). Speaking French is not mandatory at the time of recruitment. academicpositions.com/ad/institut-gu…

Dr Baudin de Gustave Roussy publie, de la part du réseau français ENDOCAN-COMETE et du réseau européen ENSAT, la première étude randomisée internationale dans le domaine des phéochromocytomes et paragangliomes métastatiques (PPM) dans The Lancet. 🔗 gustaveroussy.fr/fr/une-publica…


Aujourd'hui, nous célébrons les femmes qui font la force de Gustave Roussy. 👩⚕️ Médecins, chercheuses, IDE, aides-soignantes, techniciennes, administratives et bien + encore : elles contribuent avec talent et dévouement à la mission de notre centre : #GuérirLeCancerAu21eSiècle.


@Jfhod2024 📣Positive result from PACHA 01 phase 2 RCT 📣 🔍HAI vs IV oxaliplatin after resection 4 or more CRLM 🔎 ‼️ HAI improves hepatic RFS (HR 0.63) 🧨but also DFS and trend for OS 🙌🙌 👉Phase 3 study soon ! Prodigè Group Gustave Roussy

📰 L'ostéosarcome, un #cancer rare des jeunes. Un article à retrouver sur Doctissimo, écrit en collaboration avec Nathalie Gaspar, pédiatre oncologue à Gustave Roussy 👇 doctissimo.fr/sante/maladies…

Une étude publiée dans NEJM montre que l'hystérectomie simple constitue une alternative à la chirurgie élargie pour traiter certains #cancer du col de l'utérus nejm.org/doi/10.1056/NE… La docteur @AMaulard de Gustave Roussy revient sur ces résultats lequotidiendumedecin.fr/specialites/ca…

🎓 Les inscriptions au DU de Carcinologie clinique de Gustave Roussy et Faculté de Médecine Paris-Saclay sont ouvertes. Il s’adresse aux médecins ainsi qu’aux internes en médecine, amenés à participer à la prise en charge des patients atteints de #cancer Inscription : tinyurl.com/2c9fhax6





🎓 Inscrivez-vous au DIU Tumeurs neuroendocrines de Gustave Roussy, Université Paris-Saclay et Université Paris Cité. Il propose une formation complémentaire et fait appel à des compétences en biologie, imagerie, génétique, chirurgie, et bien d’autres. tinyurl.com/2zb5jbjd #cancer




🔹Gustave Roussy at #ESMO24🔹 Personalised treatments for soft tissue sarcomas by Dr Benjamin Verret. Read press release ⤵ gustaveroussy.fr/en/esmo-2024-p…

🎓 Il reste des places pour vous inscrire au DIU Tumeurs endocrines de Gustave Roussy, Université Paris-Saclay et Université Paris Cité Formez-vous dans ce domaine faisant appel à des compétences en biologie, imagerie, génétique, chirurgie... Inscription : tinyurl.com/2zb5jbjd #Cancer